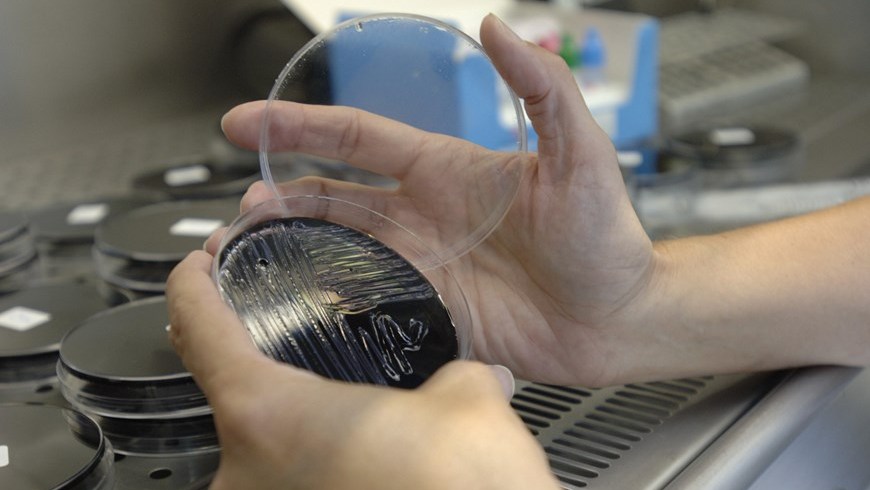
legionela

Tres personas murieron hoy a causa del brote de legionela detectado en Portugal, lo que eleva a cuatro el total de fallecidos, y a más de 100 el de hospitalizados, algunos en estado crítico.
Dos de las muertes confirmadas hoy -de un hombre de 66 años y una mujer de 81-, se produjeron en el hospital de Vila Franca de Xira, a unos 30 kilómetros al este de la capital lusa, donde se detectó el brote.
La tercera se registró en Lisboa, en uno de los centros hospitalarios de la capital a los que están siendo trasladados algunos pacientes de Vila Franca de Xira.
A este balance hay que añadir otro fallecimiento, registrado este sábado, de un hombre de 59 años.
La autoridades sanitarias lusas continúan, mientras tanto, tratando de averiguar el origen del brote de esta bacteria, que tiene su hábitat natural en el agua y, en particular, en los residuos acuosos de aparatos de aire acondicionado, duchas y sanitarios.
La legionela presenta dos formas clínicas: la infección pulmonar o “Enfermedad del Legionario”, que se caracteriza por neumonía con fiebre alta, y la forma no neumónica conocida como “Fiebre de Pontiac”, que es más leve.
Si la patología se trata a tiempo, el índice de mortalidad no supera el 6 %.
No se contagia de persona a persona, al beber agua ni a través de los alimentos, sino que para resultar infectado se ha de inhalar agua pulverizada en forma de aerosol, como gotas minúsculas.
Sus manifestaciones clínicas se parecen a las de las neumonías atípicas, con una sintomatología respiratoria variable (que al principio puede incluso confundirse con la gripe), así como alteraciones de diversos órganos, que pueden ser más o menos severas en función del estado previo del afectado. EFE
- Compartir:
- Compartir en Facebook
- Compartir en X (Twitter)
- Compartir en WhatsApp
- Comentarios